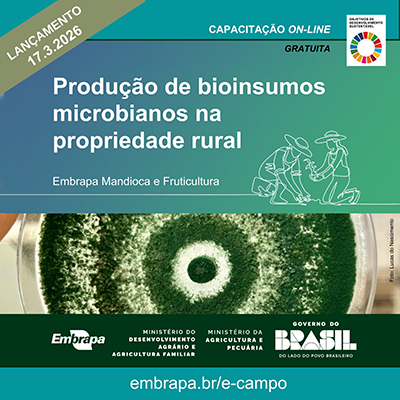
Embrapa lança capacitação on-line gratuita sobre produção de bioinsumos na propriedade rural

Embrapa lança capacitação on-line gratuita sobre produção de bioinsumos na propriedade rural
Capacitar agricultores familiares, cooperativas rurais e agentes de assistência técnica e extensão rural a compreender e aplicar os fundamentos técnicos, práticos e legais necessários para produzir e utilizar bioinsumos microbianos de forma segura, eficiente e sustentável nas próprias propriedades é o objetivo do novo curso on-line gratuito da plataforma e-Campo, a vitrine de capacitações a distância da Empresa Brasileira de Pesquisa Agropecuária – Embrapa, vinculada ao Ministério da Agricultura e Pecuária (Mapa).
O lançamento será na próxima terça (17) e integra a programação da Feira Nacional de Máquinas e Tecnologias para a Agricultura Familiar, realizada pela Embrapa em conjunto com o Ministério do Desenvolvimento Agrário e Agricultura Familiar (MDA), de 16 a 18 de março, em Campinas (SP).
Conforme a Lei 15.070/2024, bioinsumo é um produto, processo ou tecnologia de origem vegetal, animal ou microbiana, destinado ao uso na produção, armazenamento e beneficiamento de produtos agropecuários, nos sistemas de produção agrícolas, pecuários, aquícolas ou florestais, que interfira positivamente no crescimento, desenvolvimento e mecanismo de resposta de animais, plantas, microrganismos e substâncias derivadas.
No caso dessa capacitação, o foco é a produção na propriedade (on farm) de bioinsumos de microrganismos. Para a produção própria, faz-se necessária a adoção de padrões de qualidade e pureza no processo de multiplicação desses microrganismos, evitando assim a contaminação do ambiente e do homem e garantindo a efetividade do produto.
Desenvolvido pela Embrapa Mandioca e Fruticultura (BA) em parceria com o MDA, o curso “Produção de bioinsumos microbianos na propriedade rural” é realizado sem tutoria e assíncrono, permitindo ao participante acessar o conteúdo quando tiver disponibilidade. A capacitação foi estruturada em três módulos, totalizando 12 horas: Entendendo os microrganismos e sua multiplicação na propriedade; A nova lei de bioinsumos e o que ela muda na prática; e Segurança, benefícios e cuidados na produção dentro da propriedade para consumo próprio. Os módulos serão liberados por semana, o primeiro no lançamento e os demais nas semanas seguintes.
Ao final do curso, esperamos que o participante seja capaz de identificar os conceitos básicos sobre microrganismos benéficos, suas funções no solo e nas plantas e os princípios técnicos para sua multiplicação e uso prático no sistema de produção rural; relacionar os principais pontos da legislação que orienta e regula a produção, o uso e a responsabilidade sobre bioinsumos produzidos na propriedade rural, além de reconhecer os principais benefícios do uso de bioinsumos na agricultura familiar e identificar os cuidados, proibições e boas práticas exigidas pela legislação para garantir uma produção segura, eficaz e dentro das normas legais”, pontua o pesquisador Harllen Alves, coordenador técnico do projeto, que tem como gestora a técnica Olga Lins, do Setor de Gestão de Transferência de Tecnologia. Os demais conteudistas são o pesquisador Fernando Haddad e o analista Leandro Rocha.
Parceria com o MDA
Considerando a missão da Embrapa de viabilizar soluções de pesquisa, desenvolvimento e inovação para a sustentabilidade da agricultura em benefício da sociedade brasileira e o seu alinhamento com a agenda do MDA na promoção do desenvolvimento sustentável da agricultura familiar do País, firmou-se um Termo de Execução Descentralizada (TED) com o objetivo de apoiar ações de capacitação de técnicos da assistência técnica e extensão rural.
Dentre os objetivos do TED e-Campo MDA 2025, destaca-se a produção e oferta de dez capacitações on-line em temas previamente definidos pelo MDA, destinados aos agentes/técnicos de Ater visando contribuir para o fortalecimento da agricultura familiar, incluindo os assentados da reforma agrária, os povos indígenas, os remanescentes de quilombos e os demais povos e comunidades tradicionais. A Embrapa Mandioca e Fruticultura participou dessa chamada interna e teve aprovada a proposta “Produção de bioinsumos microbianos na propriedade rural: fundamentos e boas práticas para agricultores familiares e cooperativas“.
O curso está diretamente relacionado com a legislação e a política pública de apoio à agricultura familiar, em conformidade com a Lei 11.326/2006, alinhado com a Política Nacional de Assistência e Extensão Rural (Ater), e com os Objetivos de Desenvolvimento Sustentáveis ODS 2 (Fome Zero e Agricultura Sustentável), pois ao promover o uso de bioinsumos para crescimento de plantas e manejo de pragas, o curso fomenta sistemas de produção de alimentos mais sustentáveis e resilientes; ODS 4 (Educação de Qualidade), tendo em vista que a oferta de capacitação técnica gratuita e acessível fortalece o conhecimento técnico no campo; ODS 12 (Consumo e Produção Responsáveis), devido ao foco em produtos naturais e na redução de contaminantes químicos contribuindo para o manejo ecológico e a redução de impactos ambientais; e ODS 15 (Vida Terrestre), já que promove práticas agrícolas que conservam a biodiversidade do solo, reduzem o impacto ambiental de insumos químicos e contribuem para a gestão sustentável dos recursos naturais terrestres.
Serviço
Evento: Lançamento do curso on-line “Produção de bioinsumos microbianos na propriedade rural”, na programação da Feira de Máquinas da Agricultura Familiar
- Local: Expo Dom Pedro, Campinas (SP)
- Data: 17 de março de 2026.
- Horário: 10h (abertura do evento)
Inscrições: https://ava.sede.
- Informações: cnpmf.ecampo@embrapa.br
- Contatos da assessoria
- Embrapa Mandioca e Fruticultura
- mandioca-e-fruticultura.
imprensa@embrapa.br - Telefone: 75 3312 8160






